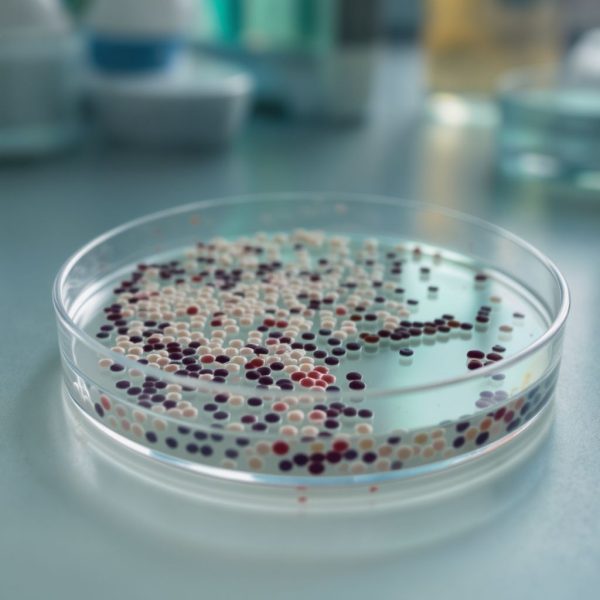

Fahéjas méz: Egy ősi kombináció a modern betegségek ellen A fahéjas méz kombinációja nem csupán egy ízletes csemege, hanem egy olyan ősi gyógyír, amelyet évezredek óta alkalmaznak a különböző kultúrák…
Turbózd fel az immunrendszered: Természetes módszerek a betegségek ellen
A modern életvitel, a felgyorsult tempó és a környezeti hatások mind-mind próbára teszik szervezetünk legfontosabb védelmi vonalát, az immunrendszerünket. Amikor az immunrendszerünk optimálisan működik, képes hatékonyan felvenni a harcot a…
A magány és a betegségek kapcsolata: Hogyan hat a társas elszigeteltség az egészségre?
A modern kor egyik legmegrázóbb paradoxona, hogy a technológiai összekapcsoltság és a globális kommunikáció soha nem látott mértékével párhuzamosan egyre többen élik meg a társas elszigeteltséget és a magányt. Ez…
A rossz bélbaktériumok által okozott rejtett betegségek
A modern orvostudomány és a táplálkozástudomány egyre nagyobb figyelmet fordít arra a több billió mikrobát számláló ökoszisztémára, amely a bélrendszerünkben él. Ez a komplex közösség, a bélflóra vagy mikrobiom, korántsem…
Női és férfi agy: Miért fenyegetik más betegségek a két nemet?
Az emberi agy egy rendkívül komplex és finomhangolt rendszer, melynek működését számtalan tényező befolyásolja. Bár sokáig egységes entitásként tekintettünk rá, a modern tudomány egyre inkább feltárja azokat a mélyreható különbségeket,…
Citrusfélékkel az elhízás és a kapcsolódó betegségek ellen
Az elhízás és a vele járó betegségek napjaink egyik legnagyobb globális egészségügyi kihívását jelentik, melyek súlyos terhet rónak az egyénekre és az egészségügyi rendszerekre egyaránt. A modern életmód, a feldolgozott…
A krónikus vízhiány és a betegségek kapcsolata: Többet iszol, mint gondolnád?
A modern ember rohanó életében gyakran elfeledkezik arról a legalapvetőbb szükségletről, amely nélkülözhetetlen létezésünk és egészségünk fenntartásához: a megfelelő hidratálásról. A víz nem csupán egy ital, hanem az élet alapja,…
A pajzsmirigy betegségeinek természetes kezelési lehetőségei
A pajzsmirigy, ez a pillangó alakú, apró szerv a nyakunk elülső részén, az egyik legfontosabb mirigy az emberi szervezetben. Számos létfontosságú funkcióért felelős, többek között az anyagcsere szabályozásáért, a testhőmérséklet…
A stressz rejtett ára: Milyen betegségeket okozhat a folyamatos feszültség?
A modern életvitel, a felgyorsult tempó és a folyamatos elvárások sokak számára teszik a stresszt mindennapos, szinte elkerülhetetlen társává. Ami evolúciós szempontból egykor létfontosságú reakció volt – a „harcolj vagy…
Fekélyes vastagbélgyulladás (UC) – Tünetek, okok, kockázati tényezők, étrendi és életmódbeli tanácsok
Fekélyes vastagbélgyulladás (UC) tünetei, okai, kockázati tényezők, diagnózis, kezelési lehetőségek, étrendi és életmódbeli tanácsok.